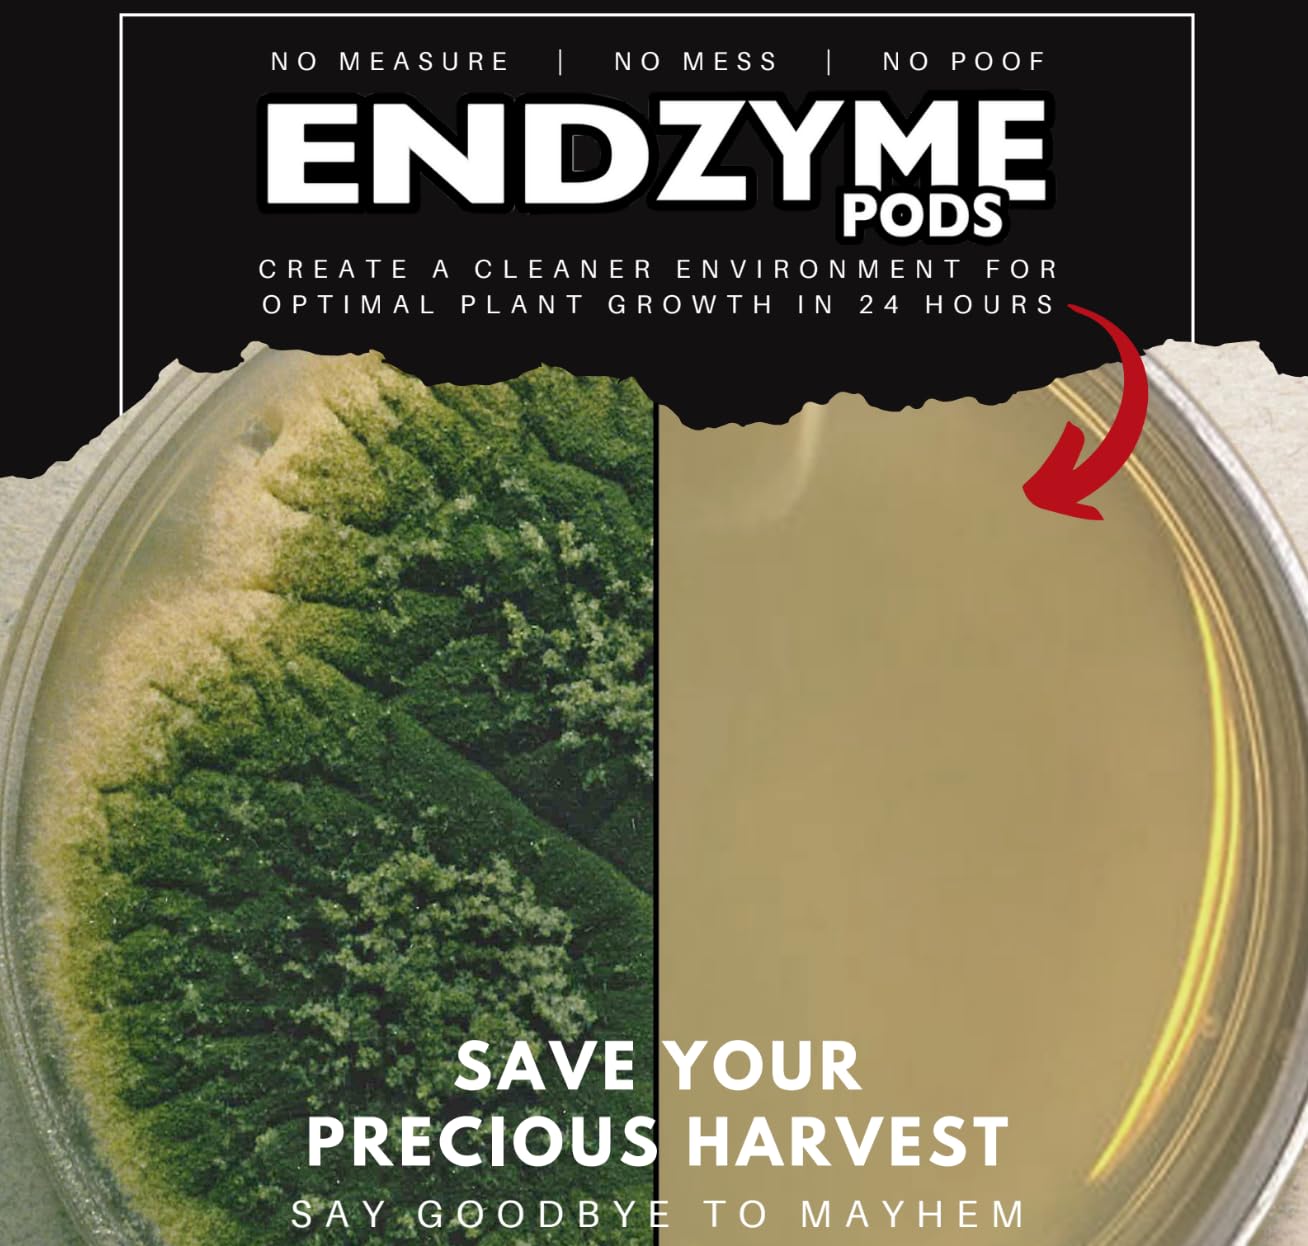

Key To Life - Endzyme Pods – Soluble Hydroponic System Cleaner & Root Zone Conditioner – Enzymatic Line Cleaner, Foliar Wash & Nutrient Optimizer – Boosts Yields +15%
 Limited Time Sale
Limited Time SaleUS$35.97 cheaper than the new price!!
Free cash-on-delivery fees for purchases over $99
Product details
| Management number | 210763692 | Release Date | 2026/04/02 | List Price | US$23.98 | Model Number | 210763692 | ||
|---|---|---|---|---|---|---|---|---|---|
| Category | |||||||||
Unlock the Full Potential of Your Grow with ENDzyme Commercial growers and hobbyists know that a clean system is the foundation of a high-yielding harvest. ENDzyme provides a professional-grade, bio-active enzymatic cleaning solution in a convenient, ultra-concentrated soluble pod. The Enzymatic Advantage unlike harsh chemical cleaners that strip your system, ENDzyme utilizes aerobic bacteria and advanced enzymes to target the root cause of system inefficiency: organic debris, salt buildup, and dead root matter. By breaking these down, ENDzyme prevents "lockout" and ensures your plants absorb the nutrients you feed them. Versatile 3-in-1 Solution System Maintenance: Keep reservoirs, pumps, and drip lines free of sludge and salt scaling. Root Zone Conditioning: Turns dead root matter into usable food for your plants, keeping the rhizosphere clean and aerobic. Foliar Wash: A superior leaf cleaner that washes away unsightly residue and dirt, leaving your final harvest clean and pristine. Safe to spray through bloom and on the day of harvest. Directions for Use: System Maintenance: 1 Pod per 100 gallons (weekly) or 1 Pod per 500 gallons (continuous). Heavy Cleaning / Foliar Wash: 1 Pod per 2–4 gallons of water. Direct Injection: See label for specific dosing (compatible with 1:100 injectors). Important: If using Reverse Osmosis (RO) water, buffer water to approx 200ppm (0.2–0.4 EC) with CalMag or base nutrient before adding ENDzyme. Do not mix directly with H2O2 or Hypochlorous Acid. Why Choose ENDzyme? With a 5-year shelf life and a highly concentrated dry formula, ENDzyme outperforms liquid enzyme products in both cost and longevity. Stop shipping water and start cleaning smarter.
- ADVANCED HYDROPHONIC SYSTEM CLEANER: Powerful bio-activated enzymatic formula designed to scrub irrigation lines, emitters, tanks, and pumps. ENDzyme actively breaks down mineral salts, sludge, and organic buildup that causes clogging. Keeps systems flowing freely and reduces maintenance downtime compared to traditional line cleaners.
- MAXIMIZES NUTRIENT UPTAKE & YIELD: By breaking down complex nutrients and dead root matter, ENDzyme makes essential minerals more bio-available to your plants. This efficiency allows growers to potentially lower input EC by 15% while seeing up to 15% increases in yield. Promotes vigorous root zones and overall plant vitality.
- PREMIUM LEAF WASH & FOLIAR CLEANER: Safe for use up to the day of harvest. Use as a foliar spray to gently wash away dust, dirt, and surface residue from foliage. Helps polish final plant matter and organically preserve quality without using harsh chemicals. Effectively cleans plant surfaces to maximize light absorption and photosynthesis.
- ULTRA-CONCENTRATED SOLUBLE PODS: Stop paying for water. Our pre-dosed 1 oz soluble pods are 5X more cost-effective than liquid competitors. 1 Pod treats up to 750 gallons for system maintenance or 2 gallons for heavy-duty foliar cleaning. Shelf-stable for 5+ years—far longer than liquid enzymatic products.
- SAFE & VERSATILE COMPATIBILITY: Compatible with most base nutrient programs and safe for all grow media. Ideal for flushing systems or as a direct replacement for harsh chemical cleaners (do not mix with H2O2 or chlorine). Note: For RO water, buffer to 0.2–0.4 EC (using CalMag or base) before adding ENDzyme for optimal activation.
| UPC | 850000255265 |
|---|---|
| Coverage | Full |
| Item Form | Tablets |
| Brand Name | Key To Life |
| Item Weight | 8 ounces |
| Manufacturer | Key to Life |
| Target Species | Houseplants, Indoor Outdoor Vegetables, Flower Plant Feed |
| Specific Uses For Product | Houseplants, Vegetables, Hydroponic |
Correction of product information
If you notice any omissions or errors in the product information on this page, please use the correction request form below.
Correction Request Form